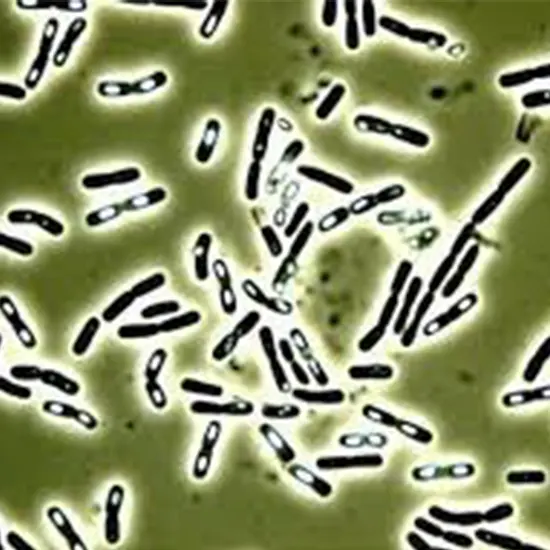

Book Bacillus Cereus Appointment Online Near me at the best price in Delhi/NCR from Ganesh Diagnostic. NABL & NABH Accredited Diagnostic centre and Pathology lab in Delhi offering a wide range of Radiology & Pathology tests. Get Free Ambulance & Free Home Sample collection. 24X7 Hour Open. Call Now at 011-47-444-444 to Book your Bacillus Cereus at 50% Discount.
Bacillus cereus is a Gram-positive, spore-forming bacterium that is found in various environments, including soil, dust, and food. It is known to be a common cause of foodborne illness, causing gastroenteritis and food poisoning in humans.
B. cereus produces heat-resistant spores that can survive in food and withstand cooking temperatures. When contaminated food is consumed, the spores can germinate and release toxins that cause illness. B. cereus produces two types of toxins: emetic toxin, which causes vomiting, and enterotoxin, which causes diarrhea.
The symptoms of B. cereus food poisoning typically include nausea, vomiting, diarrhea, which can occur within a few hours after consuming contaminated food. In most cases, the illness is self-limited and resolves on its own without specific treatment. However, in severe cases or in vulnerable populations such as infants, elderly individuals, pregnant women, and immunocompromised individuals, complications may occur and medical attention may be needed.
Diagnosis of B. cereus food poisoning is usually based on clinical symptoms and a history of consuming contaminated food. Laboratory testing, such as bacterial culture and toxin detection, can also be performed to confirm the presence of B. cereus and its toxins in food or in clinical samples.
|
Blood Culture and Sensitivity (C/S) Test |
350 | |
|
Gram Stain |
175 | |
|
Stool Examination, Routine |
60 | |
|
Stool Culture |
375 | |
| Total Price | 960 |
| Test Type | Bacillus Cereus |
| Includes | Bacillus Cereus |
| Preparation | |
| Reporting | Within 24 hours* |
| Test Price |
₹ 960
|

Early check ups are always better than delayed ones. Safety, precaution & care is depicted from the several health checkups. Here, we present simple & comprehensive health packages for any kind of testing to ensure the early prescribed treatment to safeguard your health.